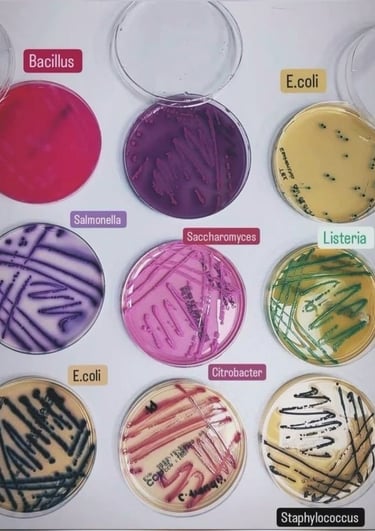
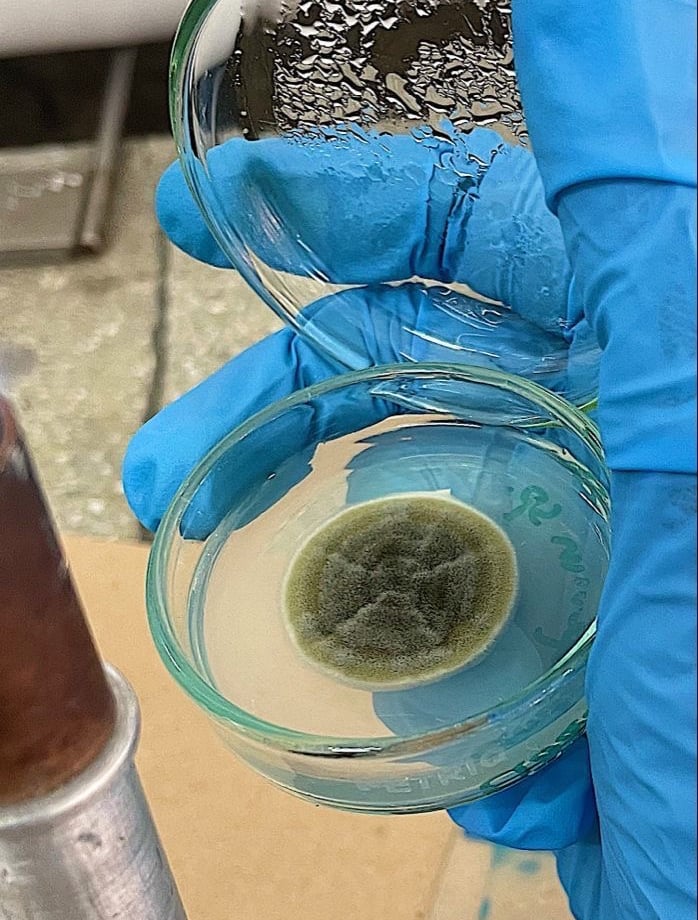

LABORATOIRE D'ANALYSES MÉDICALES BOUKHALEF
Un service professionnel, un accompagnement humain et des résultats sur lesquels vous pouvez compter.


Médecin biologiste, avec plus de 12 ans d’expertise, met son savoir-faire au service d’analyses médicales précises, rapides et fiables.
Ancien médecin biologiste au Centre Hospitalier Universitaire (CHU) de Casablanca
Ancien médecin biologiste à l’Hôpital Sekkat de Casablanca.
Il a construit son expérience au sein de structures hospitalières de référence.
Aujourd’hui, il accompagne ses patients avec rigueur, proximité et exigence, en plaçant la qualité, la sécurité et l’innovation au cœur de son laboratoire
Dr. Driss Razdi
Nos Services
Analyses biologiques de qualité, réalisées par des professionnels
🏠︎ À DOMICILE
Vous ne pouvez pas vous déplacer ? Un infirmier qualifié se rend chez vous pour effectuer vos prélèvements avec confort et discrétion.
Un service pratique, idéal pour les personnes âgées, les enfants, les femmes enceintes oules agendas chargés


🔬︎ AU LABORATOIRE
Nous vous accueillons dans un espace moderne et parfaitement équipé pour réaliser vos analyses en toute confiance
Prélèvements rapides, équipe expérimentée et résultats fiables dans les meilleurs délais.
Votre santé est notre priorité.
Nous réalisons les prélèvements directement au sein de votre entreprise pour faciliter l’accès aux analyses de vos salariés.
Nous proposons également des conventions sociales et la facturation directe à votre société pour une gestion simple et transparente.
🏢︎ EN ENTREPRISE




Nos engagements
Fiabilité
Des analyses précises réalisées avec des équipements modernes et conformes aux normes de qualité.
Vos données médicales sont protégées et accessibles uniquement via un espace sécurisé
Des délais de résultats optimisés, sans compromis sur la rigueur scientifique.
Confidentialité
Rapidité
Une équipe à votre écoute pour vous guider et répondre à toutes vos questions.
Accompagnement








Nos analyses


HEMATOLOGIE
Étude complète des cellules sanguines : globules rouges, globules blancs et plaquettes.




BIOCHIMIE
Analyses permettant d’évaluer le fonctionnement des organes (foie, reins, cœur), le taux de sucre, de cholestérol, les enzymes et les électrolytes.
ALLERGOLOGIE


MYCOLOGIE
Recherches de champignons et levures responsables d’infections cutanées, vaginales ou digestives.


Détection génétique très précise de virus, bactéries ou mutations grâce aux techniques PCR.
BIOLOGIE MOLECULAIRE


IMMUNOLOGIE
Étude du système immunitaire pour détecter les infections, maladies autoimmunes, déficits immunitaires et anomalies inflammatoires

PARASITOLOGIE
Recherche de parasites dans les selles, le sang ou autres prélèvements.

BACTERIOLEGIE
Identification des bactéries responsables d’infections (gorge, urines, peau, infections génitales…).
HORMONOLOGIE
Hormonologie : Dosage des hormones thyroïdiennes, sexuelles, de fertilité, du stress et du métabolisme.


BIOLOGIE DE LA REPRODUCTION
Examens du sperme : Analyse des liquides séminaux et des spermatozoïdes (spermogramme) pour évaluer la fertilité masculine.
Tests sanguins pour identifier les allergies alimentaires, respiratoires, médicamenteuses ou cutanées.
Nos Espaces et Équipements
Découvrez notre environnement, nos équipements et notre équipe au service de votre santé.











Contactez-nous


En quelques clics et faites vos analyses en toute tranquillité. Notre équipe vous accueille rapidement, sans attente prolongée.
contactez-nous
Adresse
Av. Moulay Rachid, Al Irfane 1 Grp 1 RDC 1, Boukhalef, Tanger (à côté de la banque populaire)
Heures d'overture
Du lundi à vendredi : 7h30 - 19h
Samedi : 7h30 - 14 h
laboratoireboukhalef.@gmail.com
© 2025 Nurgan Agency. All rights reserved.
